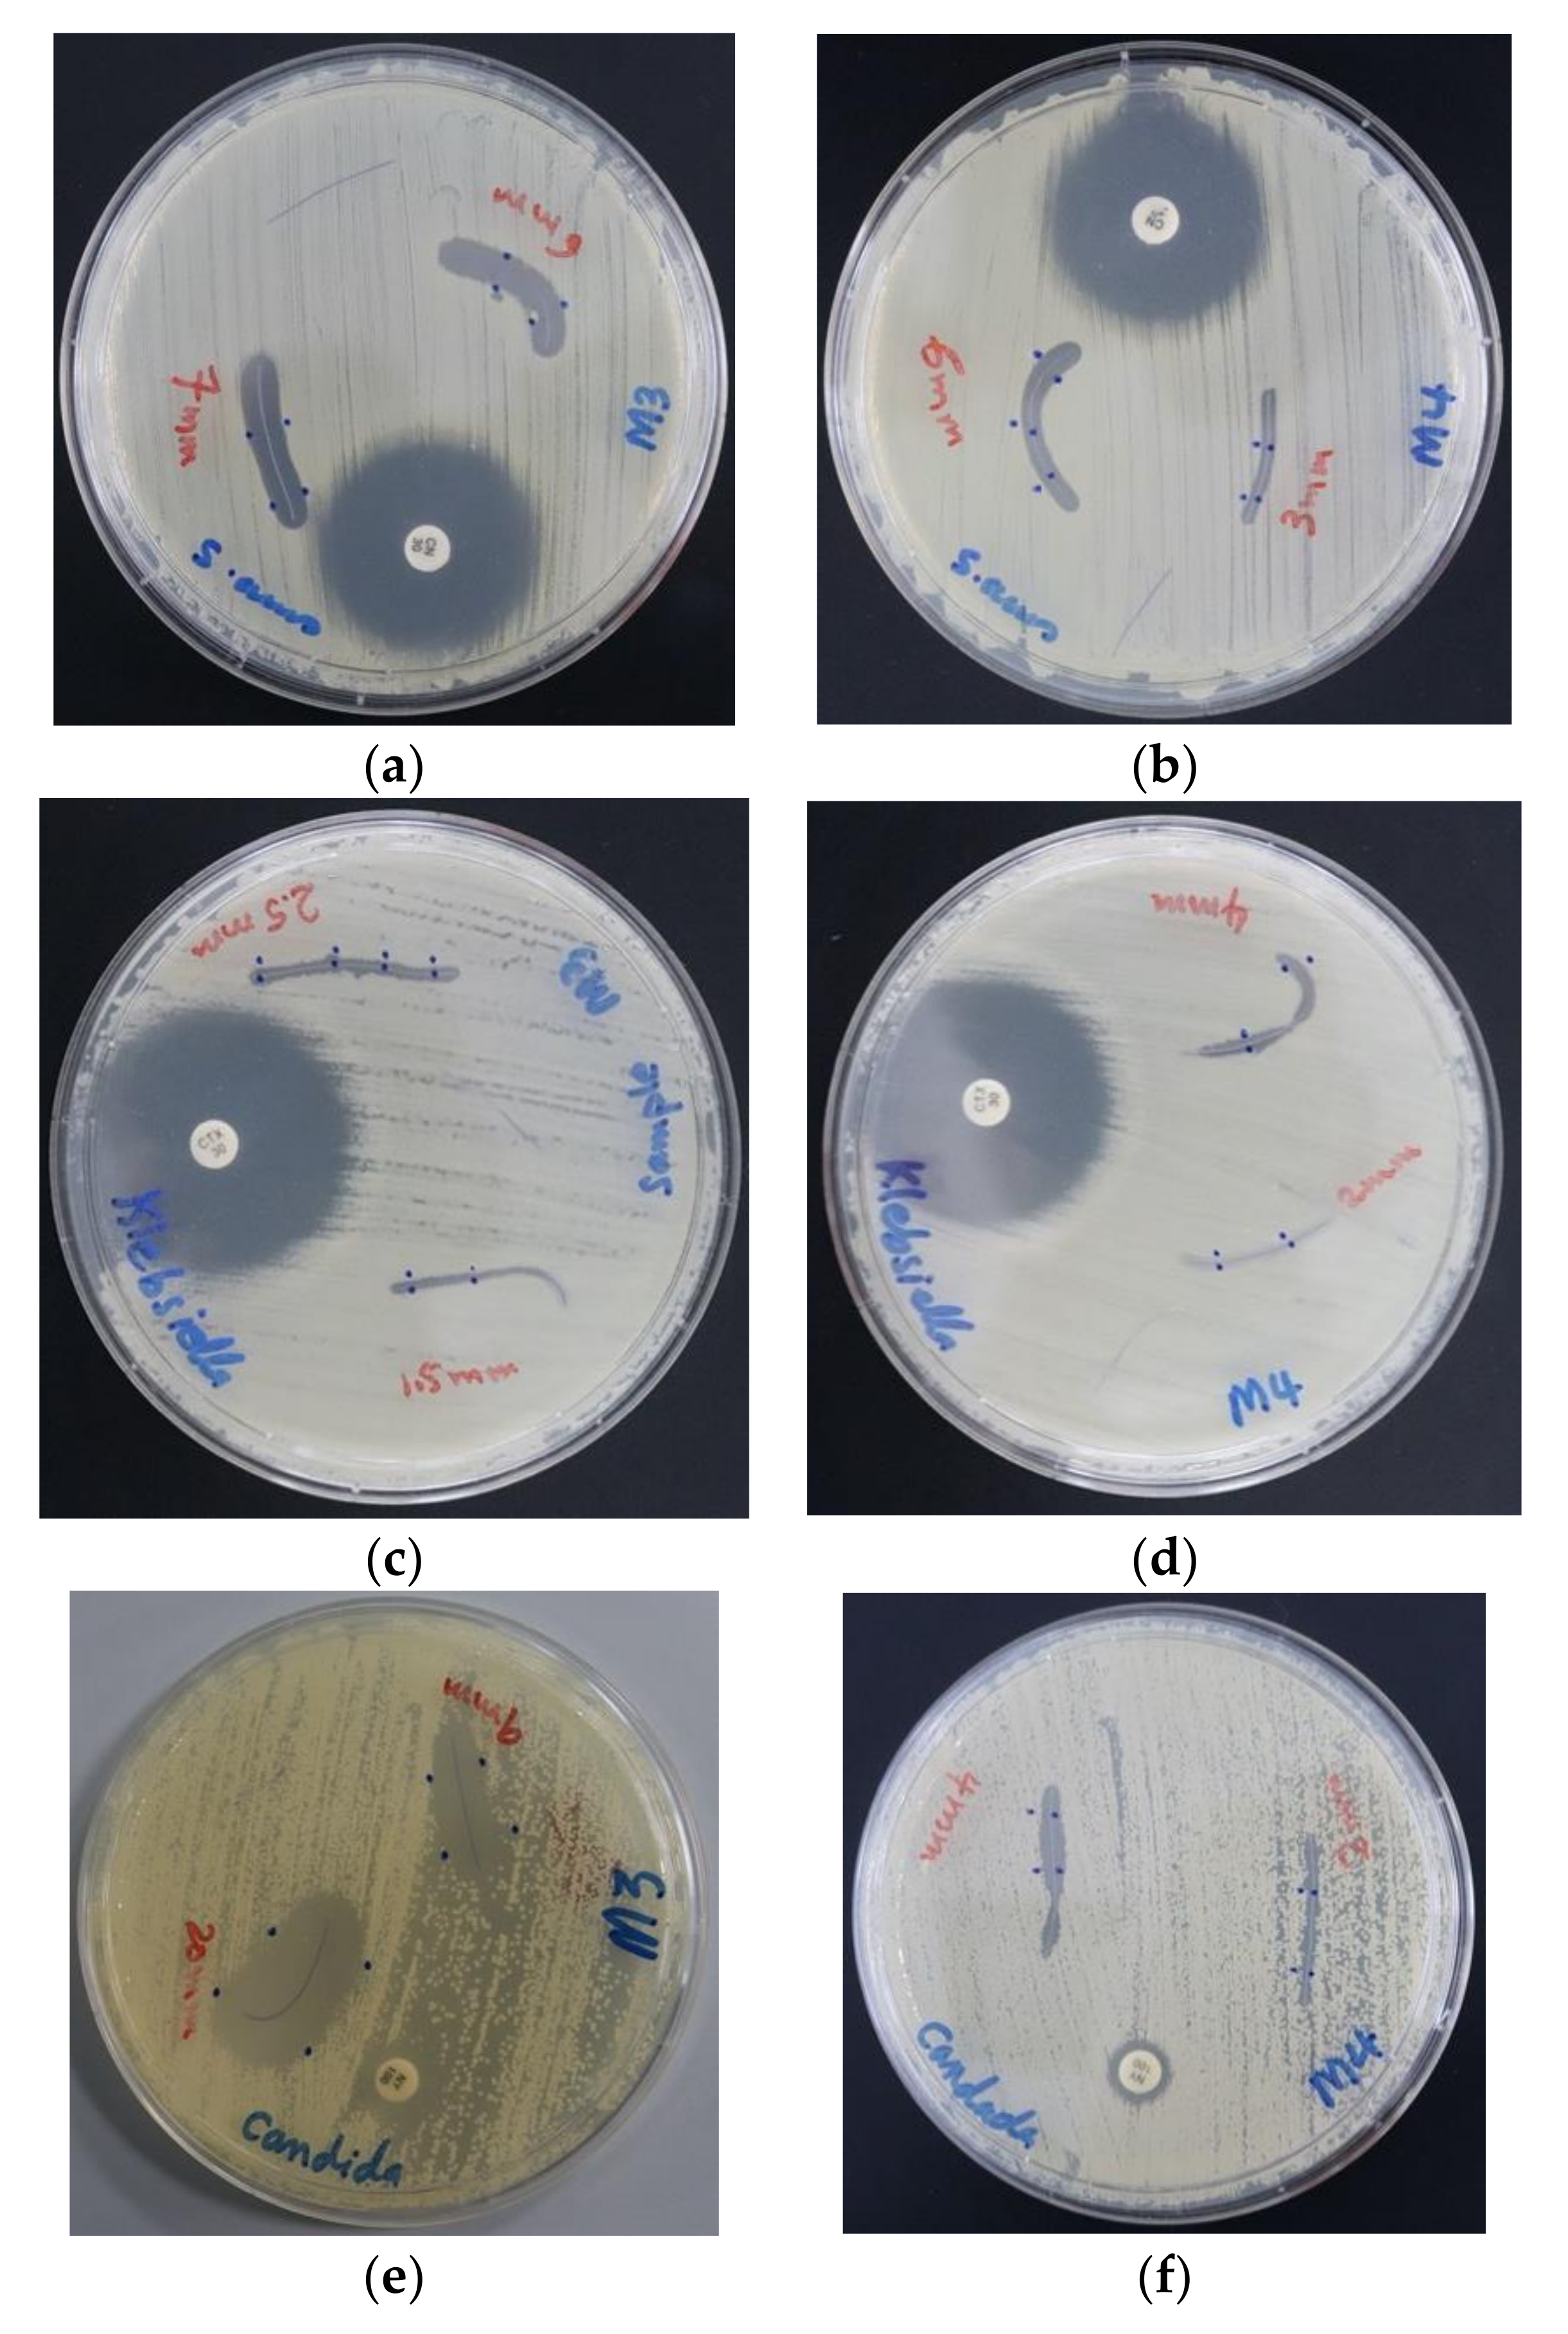
Biomimetics 05 00045 g007

Facile Synthesis of Antimicrobial Aloe Vera-“Smart” Triiodide-PVP Biomaterials
Abstract
1. Introduction
2. Materials and Methods
2.1. Materials
2.2. Preparation of Aloe vera (AV) Extract
2.3. Preparation of AV-PVP, AV-PVP-I2, AV-PVP-I2-NaI and AV-PVP-NaI
2.4. Characterization of AV Complexes
2.4.1. Scanning Electron Microscopy (SEM) and Energy-Dispersive X-ray Spectroscopy (EDX)
2.4.2. X-ray Diffraction (XRD)
2.4.3. UV-Vis Spectrophotometry (UV-Vis)
2.4.4. Fourier-Transform Infrared Spectroscopy (FT-IR)
2.5. Bacterial Strains and Culturing
2.6. Determination of Antimicrobial Properties of AV, AV-PVP-I2, AV-PVP-I2-NaI, and AV-PVP-NaI
2.6.1. Procedure for Zone of Inhibition Plate Studies
2.6.2. Disc Diffusion Method
2.7. Preparation of Dip-Coated Sutures and Their Characterization
2.8. Statistical Analysis
3. Results
3.1. Characterization of AV Complexes
3.1.1. Scanning Electron Microscopy (SEM) and Energy-Dispersive X-ray Spectroscopy (EDX)
3.1.2. X-ray Diffraction (XRD)
3.1.3. UV-Vis Spectrophotometry (UV-Vis)
3.1.4. Fourier-Transform Infrared Spectroscopy (FT-IR)
3.2. Antimicrobial Testing of AV-PVP-I2 and AV-PVP-I2-Na
3.2.1. Investigation of Antimicrobial Activities of AV-PVP-I2 and AV-PVP-I2-Na
3.2.2. Antimicrobial Activities of PGA Sutures Dip-Coated with AV-PVP-I2, AV-PVP-I2-NaI and AV-PVP-NaI
4. Discussion
5. Conclusions
Supplementary Materials
Author Contributions
Funding
Acknowledgments
Conflicts of Interest
References
- Centers for Disease Control and Prevention. Antibiotic Resistance Threats in the United States; U.S. Centers for Disease Control and Prevention: Atlanta, GA, USA, 2019.
- Cassini, A.; Hogberg, L.D.; Plachouras, D.; Quattrocchi, A.; Hoxha, A.; Simonsen, G.S.; Colomb-Cotinat, M.; Kretzschmar, M.E.; Devleesschauwer, B.; Cecchini, M.; et al. Attributable deaths and disability-adjusted life-years caused by infections with antibiotic-resistant bacteria in the EU and the European Economic Area in 2015: A population-level modelling analysis. Lancet Infect. Dis. 2019, 19, 56–66. [Google Scholar] [CrossRef]
- Shrivastava, S.; Shrivastava, P.; Ramasamy, J. World health organization releases global priority list of antibiotic-resistant bacteria to guide research, discovery, and development of new antibiotics. J. Med. Soc. 2018, 32, 76–77. [Google Scholar] [CrossRef]
- Chokshi, A.; Sifri, Z.; Cennimo, D.; Horng, H. Global Contributors to Antibiotic Resistance. J. Glob. Infect. Dis. 2019, 11, 36–42. [Google Scholar] [CrossRef] [PubMed]
- ECDC: Surveillance of Antimicrobial Resistance in Europe 2018. Available online: https://www.ecdc.europa.eu/sites/default/files/documents/surveillance-antimicrobial-resistance-Europe-2018 (accessed on 9 February 2020).
- Mulani, M.S.; Kamble, E.E.; Kumkar, S.N.; Tawre, M.S.; Pardesi, K.R. Emerging Strategies to Combat ESKAPE Pathogens in the Era of Antimicrobial Resistance: A Review. Front. Microbiol. 2019, 10, 539–563. [Google Scholar] [CrossRef] [PubMed]
- Kourtis, A.P.; Hatfield, K.; Baggs, J.; Mu, Y.; See, I.; Epson, E.; Nadle, J.; Kainer, M.A.; Dumyati, G.; Petit, S. Vital Signs: Epidemiology and Recent Trends in Methicillin-Resistant and in Methicillin-Susceptible Staphylococcus aureus Bloodstream Infections—United States. Morb. Mortal. Wkly. Rep. 2019, 68, 214. [Google Scholar] [CrossRef] [PubMed]
- Mehra, M.R.; Desai, S.S.; Ruschitzka, F.; Patel, A.N. Hydroxychloroquine or chloroquine with or without a macrolide for treatment of COVID-19: A multinational registry analysis. Lancet 2020. [Google Scholar] [CrossRef]
- Gautret, P.; Lagier, J.-C.; Parola, P.; Hoang, V.T.; Meddeb, L.; Mailhe, M.; Doudier, B.; Courjon, J.; Giordanengo, V.; Vieira, V.E.; et al. Hydroxychloroquine and Azithromycin as a treatment of COVID-19: Results of an open-label non-randomized clinical trial. Int. J. Antimicrob. Agents 2020, 105949. [Google Scholar] [CrossRef]
- Rawson, T.M.; Moore, L.S.P.; Zhu, N.; Ranganathan, N.; Skolimowska, K.; Gilchrist, M.; Satta, G.; Cooke, G.; Holmes, A. Bacterial and fungal co-infection in individuals with coronavirus: A rapid review to support COVID-19 antimicrobial prescribing. Clin. Infect. Dis. 2020. [Google Scholar] [CrossRef]
- Haj Bloukh, S.; Edis, Z.; Shaikh, A.A.; Pathan, H.M. A Look Behind the Scenes at COVID-19: National Strategies of Infection Control and Their Impact on Mortality. Int. J. Environ. Res. Public Health 2020, 17, 5616. [Google Scholar] [CrossRef]
- Vazquez-Munoz, R.; Lopez-Ribot, J.L. Nanotechnology as an Alternative to Reduce the Spread of COVID-19. Challenges 2020, 11, 15. [Google Scholar] [CrossRef]
- Rai, P.K.; Usmani, Z.; Thakur, V.K.; Gupta, V.K.; Mishra, Y.K. Tackling COVID-19 pandemic through nanocoatings: Confront and exactitude. Curr. Res. Green Sustain. Chem. 2020, 3, 100011. [Google Scholar] [CrossRef]
- Edis, Z.; Haj Bloukh, S.; Ashames, A.; Ibrahim, M. Copper-Based Nanoparticles, Their Chemistry and Antibacterial Properties: A Review. In Chemistry for a Clean and Healthy Planet; Springer International: Berlin/Heidelberg, Germany, 2019; pp. 401–428. [Google Scholar]
- Reda, M.; Ashames, A.; Edis, Z.; Bloukh, S.; Bhandare, R.; Abu Sara, H. Green Synthesis of Potent Antimicrobial Silver Nanoparticles Using Different Plant Extracts and Their Mixtures. Processes 2019, 7, 510. [Google Scholar] [CrossRef]
- Galdiero, S.; Falanga, A.; Vitiello, M.; Cantisani, M.; Marra, V.; Galdiero, M. Silver Nanoparticles as Potential Antiviral Agents. Molecules 2011, 16, 8894–8918. [Google Scholar] [CrossRef] [PubMed]
- Xiao, X.; Liu, Q.; Zhu, X.; Li, Y.; Li, X. Risk Factors Associated with Hospital-Acquired Infections for COVID-19 Patients in ICU. Lancet 2020. Preprint. Available online: https://ssrn.com/abstract=3564427 (accessed on 1 June 2020).
- Riau, A.K.; Aung, T.T.; Setiawan, M.; Yang, L.; Yam, G.H.F.; Beuerman, R.W.; Venkatraman, S.S.; Mehta, J.S. Surface Immobilization of Nano-Silver on Polymeric Medical Devices to Prevent Bacterial Biofilm Formation. Pathogens 2019, 8, 93. [Google Scholar] [CrossRef]
- Kampf, G.; Todt, D.; Pfaender, S.; Steinmann, E. Persistence of coronaviruses on inanimate surfaces and their inactivation with biocidal agents. J. Hosp. Infect. 2020, 104, 246–251. [Google Scholar] [CrossRef]
- Gao, T.; Fan, H.; Wang, X.; Gao, Y.; Liu, W.; Chen, W.; Dong, A.; Wang, Y.J. Povidone-Iodine-Based Polymeric Nanoparticles for Antibacterial applications. ACS Appl. Mater. Interfaces 2017, 9, 25738–25746. [Google Scholar]
- Blake, A.J.; Li, W.S.; Lippolis, V.; Schröder, M.; Devillanova, F.A.; Gould, R.O.; Parsons, S.; Radek, C. Template self-assembly of polyiodide networks. Chem. Soc. Rev. 1998, 27, 195–206. [Google Scholar]
- Edis, Z.; Haj Bloukh, S.; Abu Sara, H.; Bhakhoa, H.; Rhyman, L.; Ramasami, P. “Smart” triiodide compounds: Does halogen bonding influence antimicrobial activities? Pathogens 2019, 8, 182. [Google Scholar] [CrossRef]
- Kaiho, T. Iodine Chemistry and Applications, 1st ed.; Kaiho, T., Ed.; John Wiley & Sons, Inc.: Hoboken, NJ, USA, 2015; pp. 15–410. ISBN 78-1-118-46629-2. [Google Scholar]
- Vasudevan, P.; Tandon, M. Antimicrobial properties of iodine based products. J. Sci. Ind. Res. 2010, 69, 376–383. [Google Scholar]
- Viswanathan, K.; Babu, D.B.; Jayakumar, G.; Raj, G.D. Anti-microbial and skin wound dressing application of molecular iodine nanoparticles. Mater. Res. Express 2017, 4, 104003. [Google Scholar]
- Zhao, G.; He, C.; Zhou, W.; Hooper, J.P.; Imler, G.H.; Parrish, D.A.; Shreeve, J.M. Control of Biohazards: A High Performance Energetic Polycyclized Iodine-Containing Biocide. Inorg. Chem. 2018, 57, 8673–8680. [Google Scholar] [CrossRef] [PubMed]
- Haj Bloukh, S.; Edis, Z. Structure and Antimicrobial properties of bis(1,4,7,10-tetraoxacyclododecane-κ4O,O′,O′′,O′′′)cesium pentaiodide, C16H32CsI5O8. Z. Krist. NCS 2020. [Google Scholar] [CrossRef]
- Haj Bloukh, S.; Edis, Z. Halogen bonding in Crystal structure of bis(1,4,7,10-tetraoxacyclododecane-κ4O,O′,O′′,O′′′)cesium triiodide, C16H32CsI3O8. Z. Krist. New Cryst. Struct. 2020. [Google Scholar] [CrossRef]
- Edis, Z.; Bloukh, S.H. Preparation and structural and spectroscopic characterization of triiodides [M(12-crown-4)2]I3 with M = Na and Rb. Z. Nat. 2014, 69, 995–1002. [Google Scholar]
- Edis, Z.; Bloukh, S.H. Preparation and structural and spectroscopic characterization of a pentaiodide [Rb(12-crown-4)2]I5. Z. Nat. 2013, 68, 1340–1346. [Google Scholar]
- Reiss, G.J. Halogen and hydrogen bonding in the layered crystal structure of 2-iodoaniliniumtriiodide, C6H7I4N. Z. Krist. NCS 2019, 234, 899–902. [Google Scholar]
- Van Mengen, M.; Reiss, G.J. I62− Anion composed of two asymmetric triiodide moieties: A competition between halogen and hydrogen bond. Inorganics 2013, 1, 3–13. [Google Scholar] [CrossRef]
- Moulay, S. Molecular iodine/polymer complexes. J. Polym. Eng. 2013, 33, 389–443. [Google Scholar] [CrossRef]
- Schmitz, G.; Rosenblatt, L.; Salerno, N.; Odette, J.; Ren, R.; Emanuel, T.; Michalek, J.; Liu, Q.; Du, L.; Jahangir, K.; et al. Treatment data using a topical povidone-iodine antiseptic in patients with superficial skin abscesses. Data Brief 2019, 23, 103715. [Google Scholar] [CrossRef]
- Davydov, A.B.; Belyh, S.I.; Kravets, V.V. Iodine containing coating with prolonged antimicrobial activity based on water insoluble polymer matrix. Biomed. Eng. 2013, 46, 237–240. [Google Scholar] [CrossRef]
- Joseph, B.; George, A.; Gopi, S.; Kalarikkal, N.; Thomas, S. Polymer sutures for simultaneous wound healing and drug delivery—A review. Int. J. Pharmac. 2017, 524, 454–466. [Google Scholar] [CrossRef] [PubMed]
- Gallo, A.L.; Paladini, F.; Romano, A.; Verri, T.; Quattrini, A.; Sannino, A.; Pollini, M. Efficacy of silver coated surgical sutures on bacterial contamination, cellular response and wound healing. Mater. Sci. Eng. 2016, 69, 884–893. [Google Scholar] [CrossRef] [PubMed]
- Haj Bloukh, S.; Edis, Z.; Ibrahim, M.R.; Abu Sara, H. “Smart” antimicrobial nanocomplexes with potential to decrease surgical site infections (SSI). Pharmaceutics 2020, 12, 361. [Google Scholar] [CrossRef]
- Anand, U.; Jacobo-Herrera, N.; Altemimi, A.; Lakhssassi, N. A Comprehensive Review on Medicinal Plants as Antimicrobial Therapeutics: Potential Avenues of Biocompatible Drug Discovery. Metabolites 2019, 9, 258. [Google Scholar] [CrossRef]
- Zhao, Q.; Luan, X.; Zheng, M.; Tian, X.-H.; Zhao, J.; Zhang, W.-D.; Ma, B.-L. Synergistic Mechanisms of Constituents in Herbal Extracts during Intestinal Absorption: Focus on Natural Occurring Nanoparticles. Pharmaceutics 2020, 12, 128. [Google Scholar] [CrossRef]
- Zhang, D.; Gan, R.Y.; Farha, A.K.; Kim, G.; Yang, Q.Q.; Shi, X.M.; Shi, C.L.; Luo, Q.X.; Xu, X.B.; Li, H.B.; et al. Discovery of Antibacterial Dietary Spices That Target Antibiotic-Resistant Bacteria. Microorganisms 2019, 7, 157. [Google Scholar] [CrossRef]
- Manchanda, G.; Sodhi, R.K.; Jain, U.K.; Chandra, R.; Madan, J. Iodinated curcumin bearing dermal cream augmented drug delivery, antimicrobial and antioxidant activities. J. Microencapsul. 2018, 35, 49–61. [Google Scholar] [CrossRef]
- Islam, M.W.; Bloukh, S.H.; Edis, Z.; Bhandare, R.R. Emerging Phytochemicals and Bioactive Compounds from a Desert Plant Prosopis cineraria (L.) Druce and Future Prospects. In Chemistry for a Clean and Healthy Planet, 1st ed.; Ramasami, P., Gupta Bhowon, M., Jhaumeer Laulloo, S., Li Kam Wah, H., Eds.; Springer Nature AG: Cham, Switzerland, 2019; pp. 401–428. ISBN 78-3-030-20282-8. [Google Scholar] [CrossRef]
- Islam, M.W.; Hassan, N.A.; Bloukh, S.H.; Shahwan, M.; Bhandare, R.R. Exploring the Literature on Prosopis Cineraria Linn. for its Therapeutic Potential and Safety: A Review. Int. Res. J. Pharm. 2019, 10. [Google Scholar] [CrossRef]
- Sánchez, M.; González-Burgos, E.; Iglesias, I.; Gómez-Serranillos, M.P. Pharmacological Update Properties of Aloe Vera and its Major Active Constituents. Molecules 2020, 25, 1324. [Google Scholar] [CrossRef]
- Balaji, A.; Vellayappan, M.V.; John, A.A.; Subramanian, A.P.; Jaganathan, S.K.; SelvaKumar, M.; Faudzi, A.A.b.M.; Supriyanto, E.; Yusof, M. Biomaterials Based Nano-Applications of Aloe vera and its Perspective: A Review. ChemInform 2015, 46. [Google Scholar] [CrossRef]
- Jain, S.; Rathod, N.; Nagi, R.; Sur, J.; Laheji, A.; Gupta, N.; Agrawal, P.; Prasad, S. Antibacterial Effect of Aloe Vera Gel against Oral Pathogens: An In-vitro Study. J. Clin. Diagn. Res. 2016, 10, ZC41–ZC44. [Google Scholar] [CrossRef] [PubMed]
- Hamman, J.H. Composition and Applications of Aloe vera Leaf Gel. Molecules 2008, 13, 1599–1616. [Google Scholar] [CrossRef] [PubMed]
- Liu, C.; Cui, Y.; Pi, F.; Cheng, Y.; Guo, Y.; Qian, H. Extraction, Purification, Structural Characteristics, Biological Activities and Pharmacological Applications of Acemannan, a Polysaccharide from Aloe vera: A Review. Molecules 2019, 24, 1554. [Google Scholar] [CrossRef] [PubMed]
- Donkor, A.; Donkor, M.N.; Kuubabongnaa, N. Evaluation of anti-infective potencies of formulated aloin A ointment and aloin A isolated from Aloe barbadensis Miller. BMC Chem. 2020, 14, 8. [Google Scholar] [CrossRef]
- Kumar, S.; Yadav, M.; Yadav, A.; Rohilla, P.; Yadav, J.P. Antiplasmodial potential and quantification of aloin and aloe-emodin in Aloe vera collected from different climatic regions of India. BMC Complement Altern. Med. 2017, 17, 369. [Google Scholar] [CrossRef]
- Ray, A.; Aswatha, S.M. An analysis of the influence of growth periods on physical appearance, and acemannan and elemental distribution of Aloe vera L. gel. Ind. Crops Prod. 2013, 48, 36–42. [Google Scholar] [CrossRef]
- Ray, A.; Gupta, S.D. A panoptic study of antioxidant potential of foliar gel at different harvesting regimens of Aloe vera L. Ind. Crops Prod. 2013, 51, 130–137. [Google Scholar] [CrossRef]
- Borges-Argáez, R.; Chan-Balan, R.; Cetina-Montejo, L.; Ayora-Talavera, G.; Sansores-Peraza, P.; Gómez-Carballo, J.; Mirbella Cáceres-Farfán, M. In vitro evaluation of anthraquinones from Aloe vera (Aloe barbadensis Miller) roots and several derivatives against strains of influenza virus. Ind. Crops Prod. 2019, 132, 468–475. [Google Scholar] [CrossRef]
- Sun, Z.; Yu, C.; Wang, W.; Yu, G.; Zhang, T.; Zhang, L.; Zhang, J.; Wei, K. Aloe Polysaccharides Inhibit Influenza A Virus Infection—A Promising Natural Anti-flu Drug. Front. Microbiol. 2018, 9, 2338. [Google Scholar] [CrossRef]
- Minjares-Fuentes, R.; Rodríguez-González, V.M.; González-Laredo, R.F.; Eim, V.; González-Centeno, M.R.; Femenia, A. Effect of different drying procedures on the bioactive polysaccharide acemannan from Aloe vera (Aloe barbadensis Miller). Carbohydr. Polym. 2017, 168, 327–336. [Google Scholar] [CrossRef]
- Xiang, H.; Cao, F.; Ming, D.; Zheng, Y.; Dong, X.; Zhong, X.; Mu, D.; Li, B.; Zhong, L.; Cao, J.; et al. Aloe-emodin inhibits Staphylococcus aureus biofilms and extracellular protein production at the initial adhesion stage of biofilm development. Appl. Microbiol. Biotechnol. 2017, 101, 6671–6681. [Google Scholar] [CrossRef] [PubMed]
- Kumar, S.; Yadav, M.; Yadav, A.; Yadav, J.P. Comparative Analysis of Antimicrobial Activity of Methanolic Extracts of Aloe Vera and Quantification of Aloe-Emodin Collected From Different Climatic Zones of India. Arch. Clin. Microbiol. 2015, 6, 1. [Google Scholar]
- Goudarzi, M.; Fazeli, M.; Azad, M.; Seyedjavadi, S.S.; Mousavi, R. Aloe vera gel: Effective Therapeutic Agent against Multidrug-Resistant Pseudomonas aeruginosa Isolates Recovered from Burn Wound Infections. Chemother. Res. Pract. 2015, 639806. [Google Scholar] [CrossRef] [PubMed]
- Tummalapalli, M.; Berthet, M.; Verrier, B.; Deopura, B.L.; Alam, M.S.; Gupta, B. Composite wound dressings of pectin and gelatin with aloe vera and curcumin as bioactive agents. Int. J. Biol. Macromol. 2016, 82, 104–113. [Google Scholar] [CrossRef]
- Ezhilarasu, H.; Ramalingam, R.; Dhand, C.; Lakshminarayanan, R.; Sadiq, A.; Gandhimathi, C.; Ramakrishna, S.; Bay, B.H.; Venugopal, J.R.; Srinivasan, D.K. Biocompatible Aloe vera and Tetracycline Hydrochloride Loaded Hybrid Nanofibrous Scaffolds for Skin Tissue Engineering. Int. J. Mol. Sci. 2019, 20, 5174. [Google Scholar] [CrossRef] [PubMed]
- Bauer, A.W.; Perry, D.M.; Kirby, W.M.M. Single-disk antibiotic-sensitivity testing of staphylococci: An analysis of technique and results. AMA Arch. Intern. Med. 1959, 104, 208–216. [Google Scholar] [CrossRef] [PubMed]
- Clinical and Laboratory Standards Institute (CLSI). Performance Standards for Antimicrobial Disk Susceptibility Testing, 28th ed.; M100S; CLSI: Wayne, PA, USA, 2018; Volume 38. [Google Scholar]
- Aghamohamadi, N.; Sanjani, N.S.; Majidi, R.F.; Nasrollahi, S.A. Preparation and characterization of Aloe vera acetate and electrospinning fibers as promising antibacterial properties materials. Mater. Sci. Eng. C 2019, 94, 445–452. [Google Scholar] [CrossRef] [PubMed]
- Mamatha, G.; Rajulu, A.V.; Madhukar, K. In Situ Generation of Bimetallic Nanoparticles in Cotton Fabric Using Aloe Vera Leaf Extract, as a Reducing Agent. J. Nat. Fibers 2020, 17, 1121–1129. [Google Scholar] [CrossRef]
- Aziz, S.B.; Abdullah, O.G.; Hussein, S.A.; Ahmed, H.M. Effect of PVA Blending on Structural and Ion Transport Properties of CS:AgNt-Based Polymer Electrolyte Membrane. Polymers 2017, 9, 622. [Google Scholar] [CrossRef]
- Rahma, A.; Munir, M.M.; Khairurrijal, K.; Prasetyo, A.; Suendo, V.; Rachmawati, H. Intermolecular Interactions and the Release Pattern of Electrospun Curcumin-Polyvinyl (pyrrolidone) Fiber. Biol. Pharm. Bull. 2016, 39, 163–173. [Google Scholar] [CrossRef]
- Zhao, Y.; Sun, Y.N.; Lee, M.J.; Kim, Y.H.; Lee, W.; Kim, K.H.; Kim, K.T.; Kang, J.S. Identification and discrimination of three common Aloe species by high performance liquid chromatography-tandem mass spectrometry coupled with multivariate analysis. J. Chromatogr. B 2016, 1031, 163–171. [Google Scholar] [CrossRef] [PubMed]
- Froldi, G.; Baronchelli, F.; Marin, E.; Grison, M. Antiglycation Activity and HT-29 Cellular Uptake of Aloe-Emodin, Aloin, and Aloe arborescens Leaf Extracts. Molecules 2019, 24, 2128. [Google Scholar] [CrossRef]
- Sreekanth, K.; Siddaiah, T.; Gopal, N.O.; Kumar, Y.M.; Ramu, C. Optical and electrical conductivity studies of VO2+ doped polyvinyl pyrrolidone (PVP) polymer electrolytes. J. Sci. Adv. Mater. Devices 2019, 4, 230–236. [Google Scholar] [CrossRef]
- Rana, S.M.; Al Amin, R.; Uz-zaman, A.; Talukder, S.; Mia, M.N.H.; Tayyaba, S.; Hoq, M. Application of Aloe vera gel instead of silicon dioxide as organic dielectric material in microelectronics. Mater. Sci. Pol. 2015, 33, 635–638. [Google Scholar] [CrossRef]
- Fahmy, H.M.; Mosleh, A.M.; Elghany, A.A.; Shams-Eldin, E.; Abu Serea, E.S.; Ali, S.A.; Shalan, A.E. Coated silver nanoparticles: Synthesis, cytotoxicity, and optical properties. RSC Adv. 2019, 9, 20118–20136. [Google Scholar] [CrossRef]
- Pursell, J.L.; Pursell, C.J. Host-Guest Inclusion Complexation of α-Cyclodextrin and Triiodide Examined Using UV-Vis Spectrophotometry. J. Phys. Chem. A 2016, 120, 2144–2149. [Google Scholar] [CrossRef]
- Liang, Y.; Yamada, T.; Zhou, H.; Kimizuka, N. Hexakis(2,3,6-tri-O-methyl)-α-cyclodextrin-I5-complex in aqueous I− /I3− thermocells and enhancement in the Seebeck coefficient. Chem. Sci. 2019, 10, 773–780. [Google Scholar] [CrossRef]
- Asawahame, C.; Sutjarittangtham, K.; Eitssayeam, S.; Tragoolpua, Y.; Sirithunyalug, B.; Sirithunyalug, J. Formation of Orally Fast Dissolving Fibers Containing Propolis by Electrospinning Technique. Chiang Mai J. Sci. 2015, 42, 469–480. [Google Scholar]
- Brza, M.A.; Aziz, S.B.; Anuar, H.; Al Hazza, M.H.F. From Green Remediation to Polymer Hybrid Fabrication with Improved Optical Band Gaps. Int. J. Mol. Sci. 2019, 20, 3910. [Google Scholar] [CrossRef] [PubMed]
- Robin, P.; Pouget, J.P.; Comes, R.; Gibson, H.W.; Epstein, A.J. X-ray diffraction studies of iodine-doped polyacetylene. Polymer 1983, 24, 1558–1564. [Google Scholar] [CrossRef][Green Version]
- Wei, Y.J.; Liu, C.G.; Mo, L.P. Ultraviolet absorption spectra of iodine, iodide ion and triiodide ion. Guang Pu Xue Yu Guang Pu Fen Xi 2005, 25, 86–88. [Google Scholar]
- Li, N.; Shi, L.; Wang, X.; Guo, F.; Yan, C. Experimental Study of Closed System in the Chlorine Dioxide-Iodide-Sulfuric Acid Reaction by UV-Vis Spectrophotometric Method. Int. J. Analyt. Chem. 2011, 130102, 1–7. [Google Scholar] [CrossRef] [PubMed]
- Tran, M.; Castro, J.; O’Brien, K.R.; Pham, C.; Bird, T.H.; Iovine, P.M. Release Kinetics and Antimicrobial Properties of Iodinated Species Liberated from Physically and Chemically Modified Starch Granules. Starch 2019, 72, 1900134. [Google Scholar] [CrossRef]
- Torres-Giner, S.; Wilkanowicz, S.; Melendez-Rodriguez, B.; Lagaron, J.M. Nanoencapsulation of Aloe vera in Synthetic and Naturally Occurring Polymers by Electrohydrodynamic Processing of Interest in Food Technology and Bioactive Packaging. J. Agric. Food Chem. 2017, 65, 4439–4448. [Google Scholar] [CrossRef] [PubMed]
- Logaranjan, K.; Raiza, A.J.; Gopinath, S.C.; Chen, Y.; Pandian, K. Shape- and Size-Controlled Synthesis of Silver Nanoparticles Using Aloe vera Plant Extract and Their Antimicrobial Activity. Nanoscale Res. Lett. 2016, 11, 520. [Google Scholar] [CrossRef] [PubMed]
- Liu, W.; Cai, A.; Carley, R.; Rocchio, R.; Petrovas, Z.M.; Chartier, C.A.; Meng, X.; Su, J.; Cho, B.P.; Dain, J.A.; et al. Bioactive anthraquinones found in plant foods interact with human serum albumin and inhibit the formation of advanced glycation endproducts. J. Food Bioact. 2018, 4, 130–138. [Google Scholar] [CrossRef]
- Behboodi-Sadabad, F.; Zhang, H.; Trouillet, V.; Welle, A.; Plumeré, N.; Levkin, P.A. UV-Triggered Polymerization, Deposition, and Patterning of Plant Phenolic Compounds. Adv. Funct. Mater. 2017, 27, 1700127. [Google Scholar] [CrossRef]
- Kuntić, V.; Pejic, N.; Mićić, S. Direct Spectrophotometric Determination of Hesperidin in Pharmaceutical Preparations. Acta Chim. Slov. 2012, 59, 436–441. [Google Scholar]
- Ray, A.; Gupta, S.D.; Ghosh, S. Evaluation of anti-oxidative activity and UV absorption potential of the extracts of Aloe vera L. gel from different growth periods of plants. Ind. Crops Prod. 2013, 49, 712–719. [Google Scholar] [CrossRef]
- Miramon-Ortíz, D.A.; Argüelles-Monal, W.; Carvajal-Millan, E.; López-Franco, Y.L.; Goycoolea, F.M.; Lizardi-Mendoza, J. Acemannan Gels and Aerogels. Polymers 2019, 11, 330. [Google Scholar] [CrossRef]
- Nagaraj, G.; Brundha, D.; Kowsalya, V.; Chandraleka, C.; Sangavi, S.; Jayalakshmi, R.; Arulpriya, M.; Sathya, N.; Prasath, M.; Tamilarasu, S. Biosynthesis of zinc doped Aloe Vera for green nanoparticles. Mater. Today Proc. 2020. [Google Scholar] [CrossRef]
- Badar, Z.; Khan, S.; Ahmed, S.; Choudhary, M.I. Enhanced Production of Aloe Mannan Using Plant Biotechnology. Int. J. Biotech. Bioeng. 2017, 3, 298–316. [Google Scholar] [CrossRef][Green Version]
- Karuppuswamy, P.; Venugopal, J.R.; Navaneethan, B.; Laiva, A.L.; Sridhar, S.; Ramakrishna, S. Functionalized hybrid nanofibers to mimic native ECM for tissue engineering applications. Appl. Surf. Sci. 2014, 322, 162–168. [Google Scholar] [CrossRef]
- Lachapelle, J.M.; Castel, O.; Casado, A.F.; Leroy, B.; Micali, G.; Tennstedt, D.; Lambert, J. Antiseptics in the era of bacterial resistance: A focus on povidone iodine. Clin. Pract. 2013, 10, 579–592. [Google Scholar] [CrossRef]
- Carroll, K.C.; Morse, A.M.; Mietzner, T.; Miller, S. Jawetz, Melnick and Adelberg’s Medical Microbiology, 27th ed.; International Edition; Mc Graw-Hill Education: New York, NY, USA, 2016; ISBN 978-1-25-925534-2. [Google Scholar]
- Spitzer, M.; Robbins, N.; Wright, G.D. Combinatorial strategies for combating invasive fungal infections. Virulence 2017, 8, 169–185. [Google Scholar] [CrossRef] [PubMed]
- Kong, M.; Chen, X.G.; Xing, K.; Park, H.J. Antimicrobial properties of chitosan and mode of action: A state of the art review. Int. J. Food Microbiol. 2010, 144, 51–63. [Google Scholar] [CrossRef]
- Park, S.C.; Nam, J.P.; Kim, J.H.; Kim, Y.M.; Nah, J.W.; Jang, M.K. Antimicrobial action of water-soluble β-chitosan against clinical multi-drug resistant bacteria. Int. J. Mol. Sci. 2015, 16, 7995–8007. [Google Scholar] [CrossRef]
- Punyani, S.; Narayana, P.; Singh, H.; Vasudevan, P. Iodine based water disinfection: A review. J. Sci. Ind. Res. 2006, 65, 116–120. [Google Scholar]
- Cheng, Y.; Wang, X.; Liu, W.; Wang, D.; Chen, L. Experimental measurement and correlation of the solubility of aloe-emodin in seven pure solvents. J. Chem. Thermodyn. 2016, 98, 51–55. [Google Scholar] [CrossRef]
- Stanley, M.C.; Ifeanyi, O.I.; Okwandu Godson Eziokwu, O.G. Antimicrobial effects of Aloe vera on some human pathogens. Int. J. Curr. Microbiol. App. Sci. 2014, 3, 1022–1028. [Google Scholar]

| Strain | Antibiotic | A | 1+ | 2+ | 3+ | 4+ | 1++ | 2++ | 3++ | 4++ |
|---|---|---|---|---|---|---|---|---|---|---|
| S. pneumoniae ATCC 49619 | G | 21 | 14 | 12 | 10 | 0 | 13 | 0 | 0 | 0 |
| S. aureus ATCC 25923 | G | 28 | 25 | 20 | 19 | 8 | 20 | 13 | 11 | 0 |
| S. pyogenes ATCC 19615 | C | 25 | 16 | 10 | 0 | 0 | 10 | 0 | 0 | 0 |
| E. faecalis ATCC 29212 | CTX | 25 | 17 | 12 | 9 | 0 | 0 | 0 | 0 | 0 |
| B. subtilis WDCM 00003 | S | 20 | 22 | 17 | 10 | 0 | 16 | 11 | 8 | 0 |
| P. mirabilis ATCC 29906 | G | 35 | 0 | 0 | 0 | 0 | 0 | 0 | 0 | 0 |
| P. aeruginosa WDCM 00026 | CTX | 20 | 13 | 0 | 0 | 0 | 9 | 8 | 0 | 0 |
| E. coli WDCM 00013 | G | 23 | 18 | 13 | 11 | 0 | 12 | 10 | 8 | 0 |
| K. pneumoniae WDCM 00097 | CTX | 35 | 23 | 14 | 11 | 0 | 11 | 8 | 0 | 0 |
| C. albicans WDCM 00054 | NY | 16 | 56 | 20 | 17 | 11 | 35 | 28 | 25 | 17 ** |
| Strain | Anti-Biotic | A | AV-PVP-I2 W | AV-PVP-I2 D | AV-PVP-I2-NaI W | AV-PVP-I2-NaI D |
|---|---|---|---|---|---|---|
| S. pneumoniae ATCC 49619 | G | 21 | 2 | 1 | 1 | 0 |
| S. aureus ATCC 25923 | G | 28 | 7 | 6 | 6 | 3 |
| S. pyogenes ATCC 19615 | C | 25 | 3 | 1 | 0 | 0 |
| E. faecalis ATCC 29212 | CTX | 25 | 5 | 3 | 0 | 0 |
| B. subtilis WDCM 00003 | S | 20 | 5 | 3 | 4 | 1 |
| P. mirabilis ATCC 29906 | G | 35 | 0 | 0 | 0 | 0 |
| P. aeruginosa WDCM 00026 | CTX | 20 | 0 | 0 | 0 | 0 |
| E. coli WDCM 00013 | G | 23 | 5 | 2 | 0 | 0 |
| K. pneumoniae WDCM 00097 | CTX | 35 | 2.5 | 1.5 | 4 | 2 |
| C. albicans WDCM 00054 | NY | 16 | 20 | 9 | 4 | 2 |
| Group | AV-PVP-I2 * | AV-PVP-I2-NaI * | AV-PVP-NaI * | [22,29] | [78] | [79] | [73] | [74] | [80] | [33] |
|---|---|---|---|---|---|---|---|---|---|---|
| I2 | 205 | 203 | 203 | 460 | 460 | 205 460 | ||||
| I3- | 290 358 | 290 359 | 290 359 | 290 359 | 288 352 | 297 350 | 290 350 | 290 352 | 290 352 | |
| I- | 202 | 193 226 | 293 | 192 225 | ||||||
| PVP-I2 | 305 | 305 | 310 361 395 |
| AV Component | AV * | [Lit.] |
|---|---|---|
| Aloin | 208, 231, 268, 296, 353 | [50,68,69,82] |
| Aloe-Emodin | 226, 257, 285 | [69] |
| Aloesin | 213, 251, 296, 360 | [68] |
| 10-O-β-d-glucopyranosyl aloenin | 202, 293 | [68] |
| Rhein | 229, 295, | [83] |
| Pyrogallol | 280,349 | [84] |
| Hesperidin | 329 | [85] |
© 2020 by the authors. Licensee MDPI, Basel, Switzerland. This article is an open access article distributed under the terms and conditions of the Creative Commons Attribution (CC BY) license (http://creativecommons.org/licenses/by/4.0/).
Share and Cite
Edis, Z.; Bloukh, S.H. Facile Synthesis of Antimicrobial Aloe Vera-“Smart” Triiodide-PVP Biomaterials. Biomimetics 2020, 5, 45. https://doi.org/10.3390/biomimetics5030045
Edis Z, Bloukh SH. Facile Synthesis of Antimicrobial Aloe Vera-“Smart” Triiodide-PVP Biomaterials. Biomimetics. 2020; 5(3):45. https://doi.org/10.3390/biomimetics5030045
Chicago/Turabian StyleEdis, Zehra, and Samir Haj Bloukh. 2020. "Facile Synthesis of Antimicrobial Aloe Vera-“Smart” Triiodide-PVP Biomaterials" Biomimetics 5, no. 3: 45. https://doi.org/10.3390/biomimetics5030045
APA StyleEdis, Z., & Bloukh, S. H. (2020). Facile Synthesis of Antimicrobial Aloe Vera-“Smart” Triiodide-PVP Biomaterials. Biomimetics, 5(3), 45. https://doi.org/10.3390/biomimetics5030045
